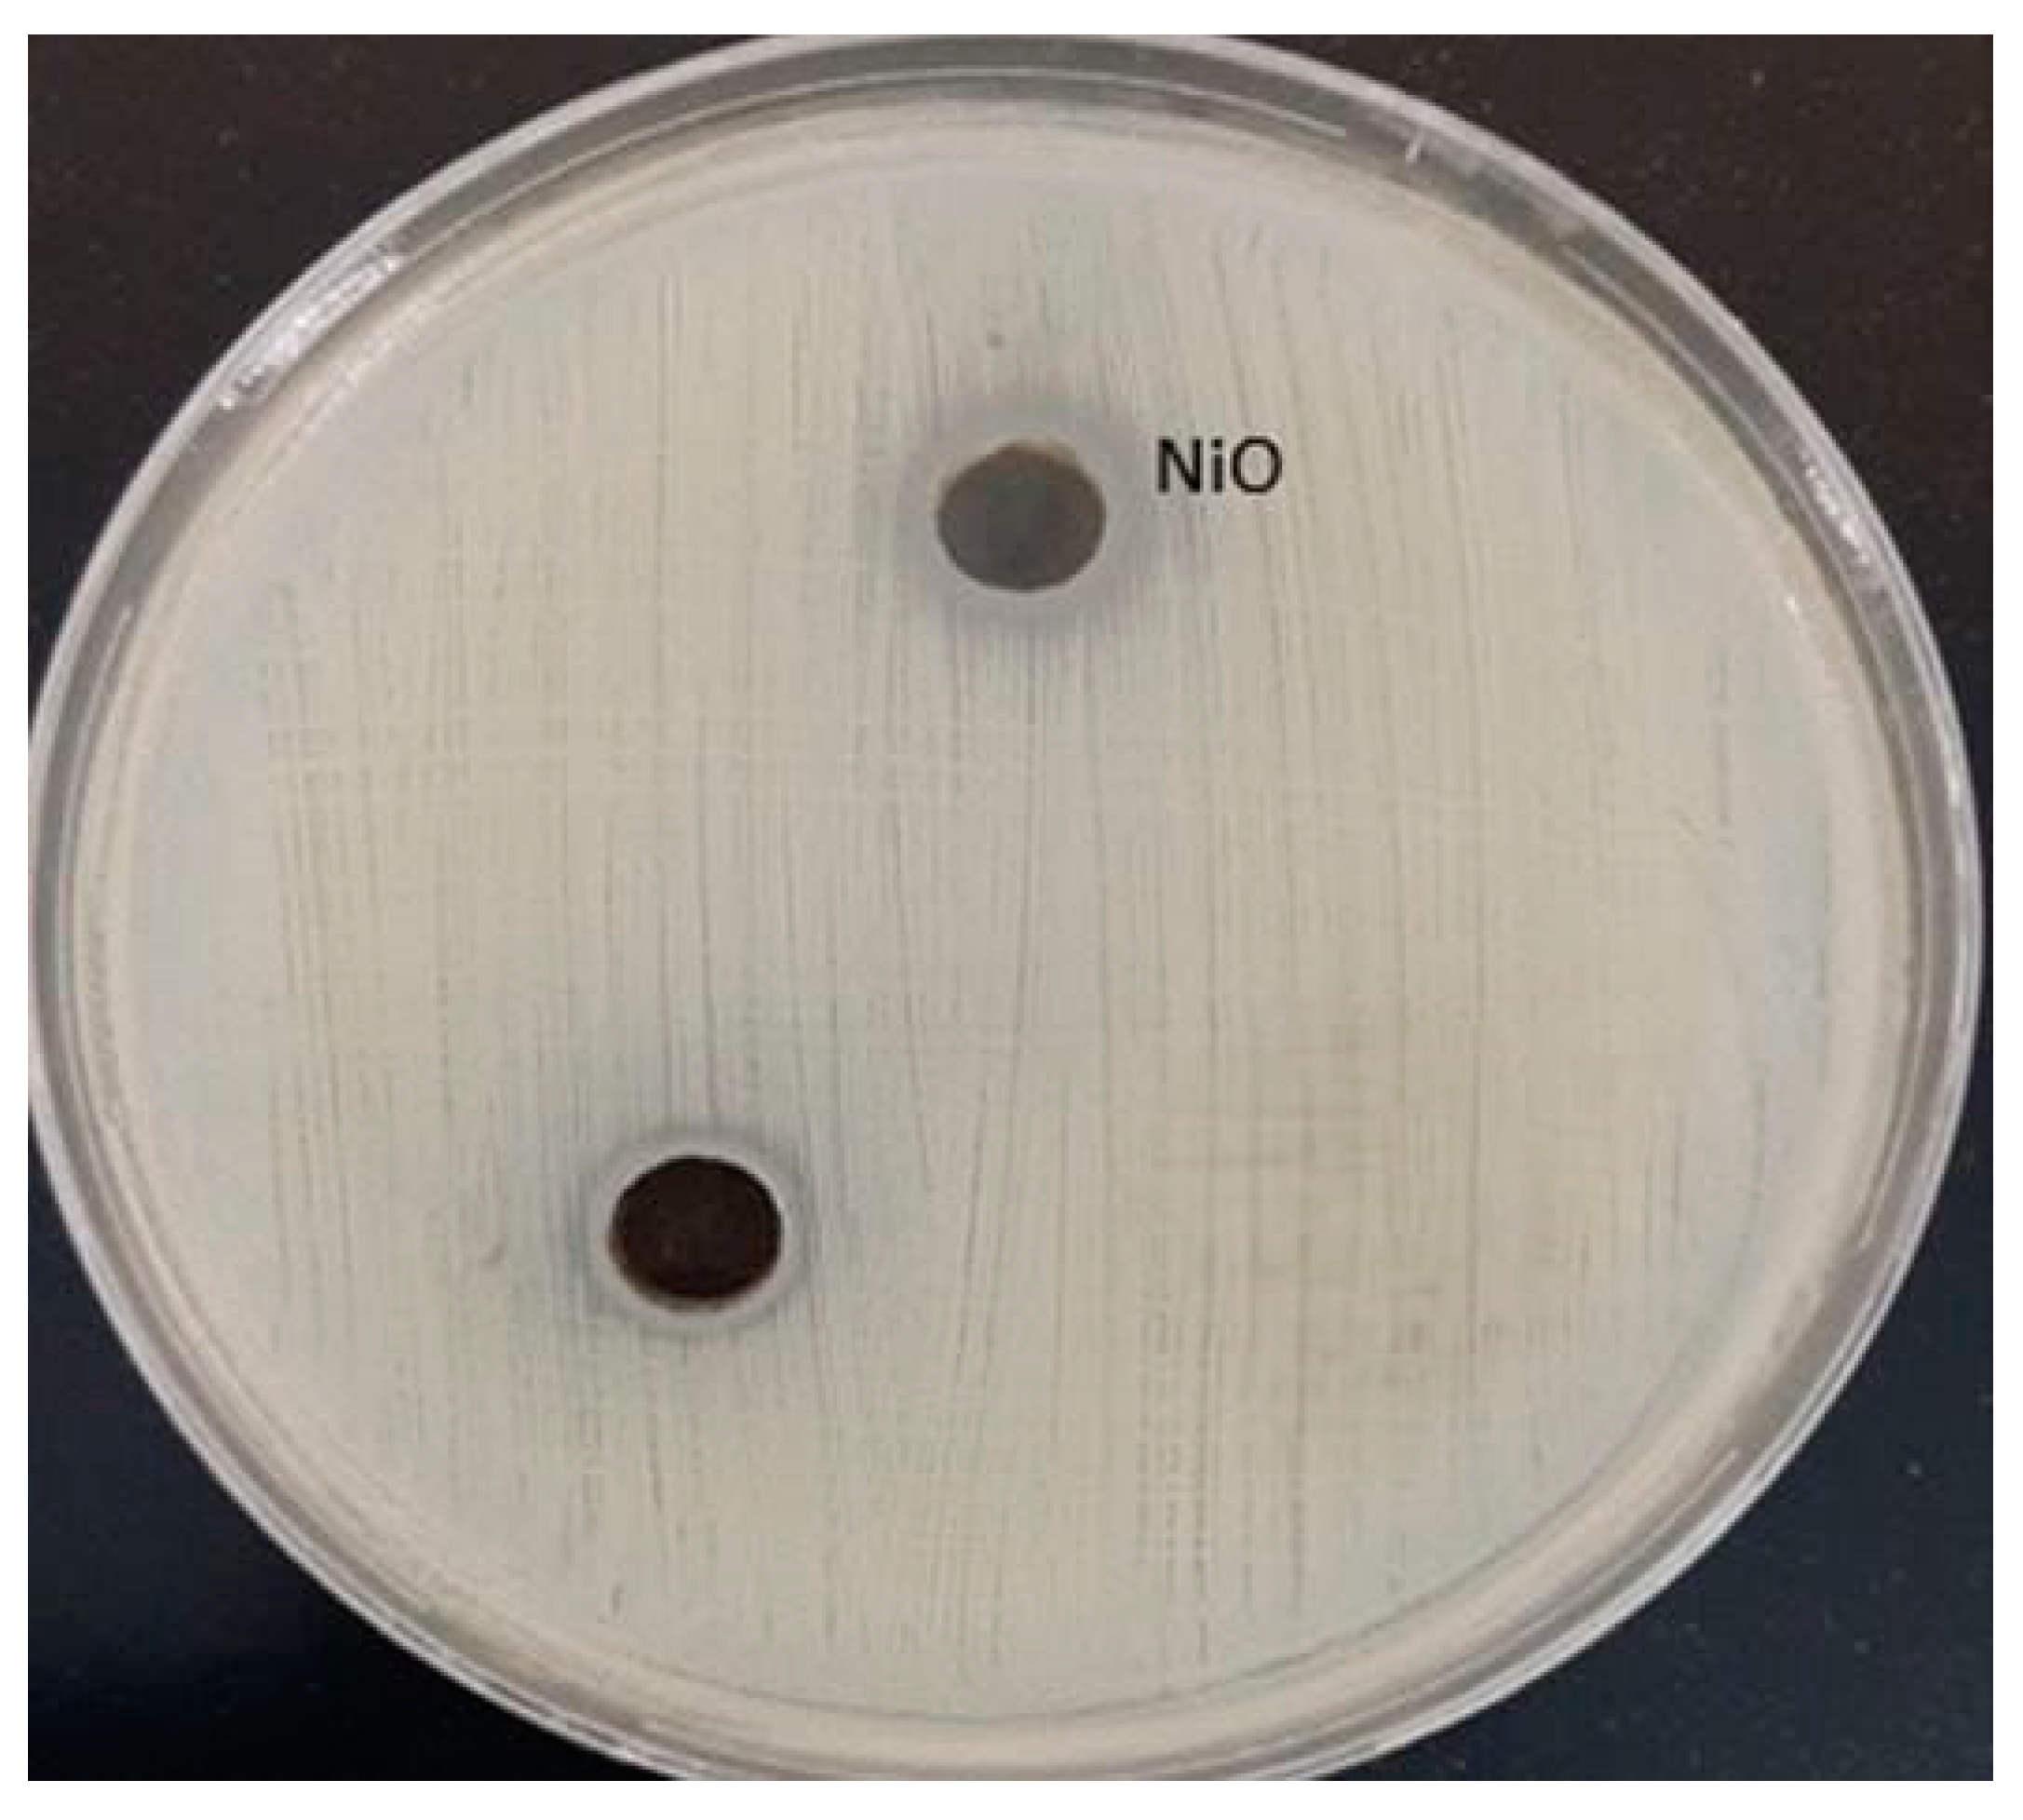
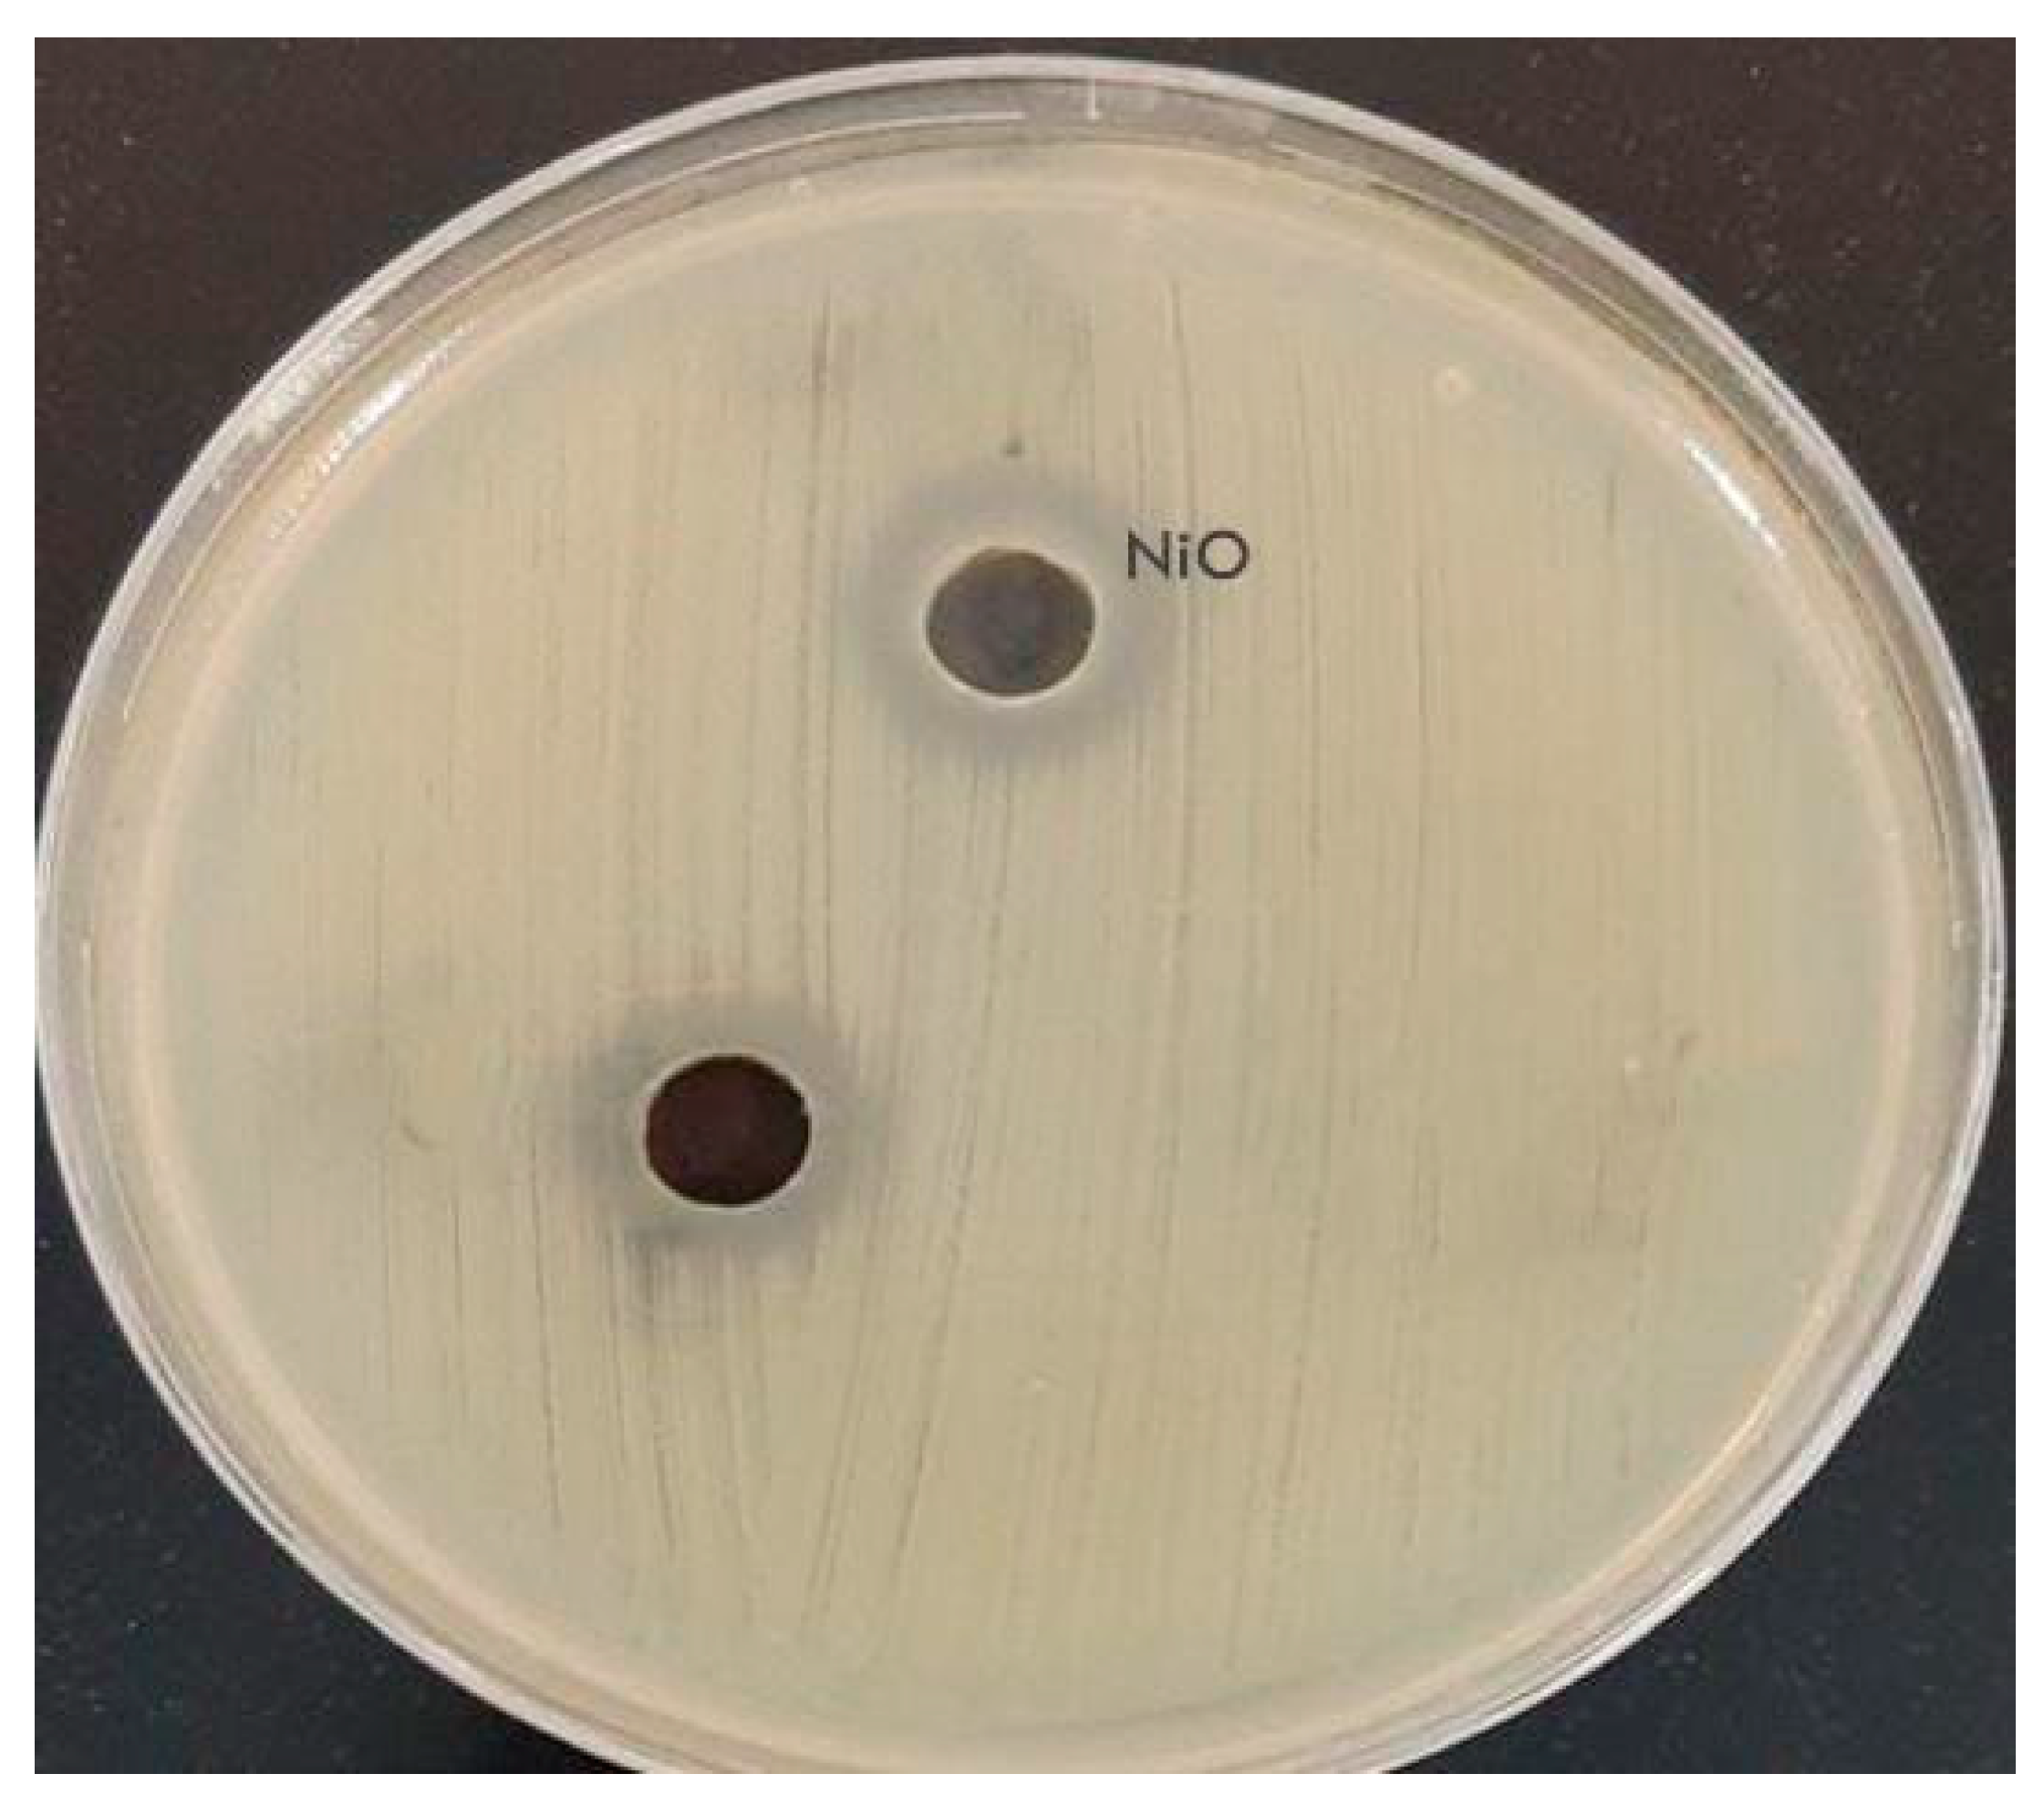

Nickel Oxide Nanoparticles Derived from Coordination Polymer of PVA and Aminobenzoic Acid Derivative: Synthesis, Characterization and Antimicrobial Activity
Abstract
1. Introduction
2. Materials and Methods
2.1. Materials
2.2. Preparation of [Ni(PVA)(P-ABA)(H2O)3]·H2O Complex
2.3. Preparation of NiO Nanoparticles
2.4. Characterization Techniques
2.5. Biological Activity
3. Results
3.1. FT-IR Spectroscopy
3.2. Electronic Spectra and Magnetic Moments
3.3. Thermal Analysis DTG & DTA
3.3.1. Thermal Decomposition of [Ni(PVA)(P-ABA)(H2O)3]·H2O (In Dynamic Air)
3.3.2. Kinetic Analysis
3.3.3. Thermodynamic Parameters of Ni(II) Complex
3.3.4. The Decomposition Rate and Stability of the Ni(II) Complex
3.3.5. Kinetic Compensation Effect

- General discussion on the thermal behavior data
3.4. X-Ray Powder Diffraction (XRD)
3.5. Electron Microscopy (SEM & TEM)
3.6. Antimicrobial Activity
4. Conclusions
Author Contributions
Funding
Data Availability Statement
Acknowledgments
Conflicts of Interest
References
- Al-Fakeh, M.S.; Al-Otaibi, N.F. Nd2O3, Cr2O3, and V2O3 Nanoparticles via Calcination: Synthesis, Characterization, Antimicrobial and Antioxidant Activities. J. Nanotechnol. 2022, 2022, 7794939. [Google Scholar] [CrossRef]
- Ohodnicki, P.; Wang, C.; Andio, M. Plasmonic transparent conducting metal oxide nanoparticles and nanoparticle films for optical sensing applications. Thin Solid Film 2013, 539, 327–336. [Google Scholar] [CrossRef]
- Vangijzegem, T.; Stanicki, D.; Laurent, S. Magnetic iron oxide nanoparticles for drug delivery: Applications and characteristics. Expert Opin. Drug Deliv. 2019, 16, 69–78. [Google Scholar] [CrossRef] [PubMed]
- Al-Fakeh, M.S.; Saleh, E.E.; Alresheedi, F. Synthesis of Novel Li2O-CuO-Bi2O3-B2O3 Glasses for Radiation Protection: An Experimental and Theoretical Study. Inorganics 2023, 11, 27. [Google Scholar] [CrossRef]
- Sunarso, J.; Hashim, S.; Zhu, N.; Zhou, W. Perovskite oxides applications in high temperature oxygen separation, solid oxide fuel cell and membrane reactor: A review. Prog. Energy Combust. Sci. 2017, 61, 57–77. [Google Scholar] [CrossRef]
- Berensmeier, S. Magnetic particles for the separation and purification of nucleic Acids. Appl. Microbiol. Biotechnol. 2006, 73, 495–504. [Google Scholar] [CrossRef]
- Al-Fakeh, M.S.; Al-Otaibi, N.F.; Alrasheedi, M.; Mohammed, A.E.M.; Alsaiari, N.A. Synthesis, antimicrobial and antioxidant activities of ZnO, PbO, and Al2O3 NPs obtained by calcining new coordination polymers. Results Chem. 2024, 11, 101840. [Google Scholar] [CrossRef]
- Ahangari, A.; Salouti, M.; Heidari, Z.; Kazemizadeh, A.; Safari, A. Development of Gentamicin-gold Nanospheres for Antimicrobial Drug Delivery to Staphylococcal Infected Foci. Drug Deliv. 2013, 20, 34–39. [Google Scholar] [CrossRef]
- Wolf, S.; Awschalom, D.; Buhrman, R.; Daughton, J.; Vonmolnar, S.; Roukes, M.; Chtchelkanova, A.; Treger, D. Spintronics: A Spin-Based Electronics Vision for the Future. Science 2001, 294, 1488–1495. [Google Scholar] [CrossRef]
- Akbari, A.; Sabouri, Z.; Hosseini, H.; Hashemzadeh, A.; Khatami, M.; Darroudi, M. Effect of nickel oxide nanoparticles as a photocatalyst in dyes degradation and evaluation of effective parameters in their removal from aqueous environments. Inorg. Chem. Commun. 2020, 115, 107867. [Google Scholar] [CrossRef]
- Khalilli, S.; Chenari, M.; Mottaghian, F. Electrospinning fabrication of nickel oxide fibers: Whole powder pattern modeling (WPPM) approach, morphology, optical and magnetic properties. Mater. Res. Bull. 2021, 140, 111305. [Google Scholar] [CrossRef]
- Liu, P.; Ng, V.M.H.; Yao, Z.; Zhou, J.; Lei, Y.; Yang, Z.; Lv, H.; Kong, L.B. Facile synthesis and hierarchical assembly of flowerlike NiO structures with enhanced dielectric and microwave absorption properties. ACS Appl. Mater. Interfaces 2017, 9, 16404–16416. [Google Scholar] [CrossRef] [PubMed]
- Al-Kadhi, N.S.; Hefnawy, M.A.; Alamro, F.S.; Pashameah, R.A.; Ahmed, H.A.; Medany, S.S. Polyaniline-supported nickel oxide flower for efficient nitrite electrochemical detection in water. Polymers 2023, 15, 1804. [Google Scholar] [CrossRef] [PubMed]
- Vyas, R.; Navin, K.; Tripathi, G.; Kurchania, R. Structural, magnetic, photocatalytic, and electrochemical studies of the mesoporous Nickel oxide (NiO) nanostructures. Optik 2021, 231, 166433. [Google Scholar] [CrossRef]
- Goel, R.; Jha, R.; Ravikant, C. Investigating the structural, electrochemical, and optical properties of p-type spherical nickel oxide (NiO) nanoparticles. J. Phys. Chem. Solids 2020, 144, 109488. [Google Scholar] [CrossRef]
- Tsai, C.; Lin, C.; Liu, Y. Increasing the Efficiency of Dye-Sensitized Solar Cells by Adding Nickel Oxide Nanoparticles to Titanium Dioxide Working Electrodes. Coating 2020, 10, 195. [Google Scholar] [CrossRef]
- Al-Fakeh, M.S.; Alsaedi, R.O.; Amiri, N.; Allazzam, G.A. Synthesis, characterization, and antimicrobial of MnO and CdO nanoparticles by using a calcination method. Coatings 2022, 12, 215. [Google Scholar] [CrossRef]
- Al-Sharabi, A.; Al-Hussam, A.M.; Abdullh, S.K.S. Synthesis and characterization of metal complexes of Cu (II) and Cd (II) with polyvinyl alcohol and studied of electrical and optical properties. Int. J. Multidiscip. Res. Dev. 2019, 6, 19–26. [Google Scholar]
- Soliman, T.S.; Vshivkov, S.A. Effect of Fe nanoparticles on the structure and optical properties of polyvinyl alcohol nanocomposite films. J. Non-Cryst. Solids 2019, 519, 119452. [Google Scholar] [CrossRef]
- Raju, C.L.; Rao, J.L.; Reddy, B.C.V.; Brahman, K.V. Thermal and IR. Studies on copper doped Poly vinyl alcohol. Bull. Mater. Sci. 2007, 30, 215–218. [Google Scholar] [CrossRef]
- Nortje, C.; van Rensburg, P.J.; Cooke, C.; Erasmus, E. The simultaneous detection and quantification of p-aminobenzoic acid and its phase 2 biotransformation metabolites in human urine using LC–MS/MS. Bioanalysis 2015, 7, 1211–1224. [Google Scholar] [CrossRef] [PubMed]
- Kadhum, W.R.; Oshizaka, T.; Ichiro, H.; Todo, H.; Sugibayashi, K. Usefulnessofliquid-crystal oral formulations to enhance the bioavailability and skin tissue targeting of p-aminobenzoic acid as a model compound. Eur. J. Pharm. Sci. 2016, 88, 282–290. [Google Scholar] [CrossRef] [PubMed]
- Al-Fakeh, M.; Amiri, N.; Al-Hakemi, A.N.; Saeed, S.E.S.; Albadri, A.E. Synthesis and properties of two Fe (III) coordination polymers based on 2-amino-4-methylthiazole, 2-mercaptobenzothiazole and aromatic polycarboxylate. Asian J. Chem. 2020, 32, 2502–2506. [Google Scholar] [CrossRef]
- El-Ghoul, Y.; Al-Fakeh, M.S.; Al-Subaie, N.S. Synthesis and Characterization of a New Alginate/Carrageenan Crosslinked Biopolymer and Study of the Antibacterial, Antioxidant, and Anticancer Performance of Its Mn(II), Fe(III), Ni(II), and Cu(II) Polymeric Complexes. Polymers 2023, 15, 2511. [Google Scholar] [CrossRef]
- George, A.; Raj, M.; Raj, D.; Irudaraj, A.; Arumgam, J.; Kumar, M.; Prabu, H.; Sundaram, S.; Al-Dhabi, N.; Arasu, M.; et al. Temperature effect on CuO nanoparticles: Antimicrobial activity towards bacterial strains. Surf. Interface 2020, 21, 100761. [Google Scholar] [CrossRef]
- Dror, I.; Fink, L.; Weiner, L.; Berkowitz, B. Elucidating the catalytic degradation of enrofloxacin by copper oxide nanoparticles through the identification of the reactive oxygen species. Chemosphere 2020, 258, 127266. [Google Scholar] [CrossRef]
- Hendrawan, H.; Khoerunnisa, F.; Sonjaya, Y.; Purti, A. Poly(vinylalcohol)/glutaraldehyde/Premna oblongifolia merr extract hydrogel for controlled-release and water absorption application. Mater. Sci. Eng. 2019, 509, 012048. [Google Scholar]
- Roik, N.; Belyakova, L. IR Spectroscopy, X-Ray Diffraction and Thermal Analysis Studies of Solid “β-Cyclodextrin—Para-Aminobenzoic Acid” Inclusion Complex. Phys. Chem. Solid State 2011, 12, 168–173. [Google Scholar]
- Al-Fakeh, M.; Alsaedi, R. Synthesis, Characterization, and Antimicrobial Activity of CoO Nanoparticles from a Co (II) Complex Derived from Polyvinyl Alcohol and Aminobenzoic Acid Derivative. Sci. World J. 2021, 2021, 6625216. [Google Scholar] [CrossRef]
- Al-Fakeh, M.S. Synthesis, thermal stability and kinetic studies of copper (II) and cobalt (II) complexes derived from 4-aminobenzohydrazide and 2-mercaptobenzothiazole. Eur. Chem. Bull. 2020, 9, 403–409. [Google Scholar] [CrossRef]
- Al-Fakeh, M. Synthesis and Characterization of Coordination Polymers of 1,3-Di(4- Pyridyl)-Propane And 2-Aminobenzothiazole with Mn(II), Co(II), Cu(II) and Ni(II) Ions. J. Chem. Pharm. Res. 2018, 10, 77–83. [Google Scholar]
- Al-Fakeh, M.S.; Allazzam, G.A.; Yarkandi, N.H. Ni(II), Cu(II), Mn(II), and Fe(II) Metal Complexes Containing 1,3-Bis(diphenylphosphino)propane and Pyridine Derivative: Synthesis, Characterization, and Antimicrobial Activity. Int. J. Biomater. 2021, 2021, 4981367. [Google Scholar] [CrossRef] [PubMed]
- Siddaiah, T.; Ojha, P.; Kumar, G.; Ramu, C. Structural, Optical and Thermal Characterizations of PVA/MAA:EA Polyblend Films. Mater. Res. 2018, 21, e20170987. [Google Scholar] [CrossRef]
- Gainar, A.; Stevens, J.; Suljoti, E.; Xiao, J.; Gonlak, R.; Aziz, E.; Schrorder, S. The Structure of P-Aminobenzoic Acid in Water: Studies Combining UV-Vis, NEXAFS and RIXS Spectroscopies. J. Phys. Conf. Ser. 2016, 712, 012034. [Google Scholar] [CrossRef]
- Al-Fakeh, M.S. Synthesis, characterization and anticancer activity of NiO nanoparticles from a Ni (II) complex derived from chitosan and pyridine derivative. Bulg. Chem. Commun. 2021, 53, 321–326. [Google Scholar]
- Agbaje, O.; Osowole, A.; Malumi, E.; Walki, S. Synthesis, Spectroscopic Characterization, Antimicrobial and Anti-oxidant Properties of Some Metal(II) Complexes of Mixed Ligands-Riboflavin and 4-Aminobenzoic Acid. Res. Rev. J. Chem. 2015, 4, 1–7. [Google Scholar]
- Coats, A.; Redfern, J. Kinetic Parameters from Thermogravimetric Data. Nature 1964, 201, 68–69. [Google Scholar] [CrossRef]
- Horowitz, H.; Gershon, M. A New Analysis of Thermogravimetric Traces. Anal. Chem. 1963, 35, 1464–1468. [Google Scholar] [CrossRef]
- Klug, H.; Alexander, L. X-Ray Diffraction Procedures for Polycrystalline and Amorphous Materials; Wiley: Hoboken, NJ, USA, 1954; p. 716. [Google Scholar]
- Al-Fakeh, M.S.; Messaoudi, S.; Alresheedi, F.I.; Albadri, A.E.; El-Sayed, W.A.; Saleh, E.E. Preparation, characterization, DFT calculations, antibacterial and molecular docking study of Co (II), Cu (II), and Zn (II) mixed ligand complexes. Crystals 2023, 13, 118. [Google Scholar] [CrossRef]
- Li, H.; Chen, Q.; Zhao, J.; Urmila, K. Enhancing the antimicrobial activity of natural extraction using the synthetic ultrasmall metal nanoparticles. Sci. Rep. 2015, 5, srep11033. [Google Scholar] [CrossRef]
- Armentano, I.; Arciola, C.; Fortunati, E.; Davide, F.; Mattioil, S.; Amoroso, C.; Rizzo, J.; Kenny, J.; Imbriani, M.; Visai, L. The interaction of bacteria with engineered nanostructured polymeric materials: A review. Sci. World J. 2014, 2014, 410423. [Google Scholar] [CrossRef] [PubMed]
- Gao, W.; Thamphiwatana, S.; Angsantikul, P.; Zhang, L. Nanoparticle approaches against bacterial infections. Wires Nanomed. Nanobiotechnol. 2014, 6, 532–547. [Google Scholar] [CrossRef] [PubMed]
- Luan, B.; Huynh, T.; Zhou, R. Complete wetting of graphene by biological lipids. Nanoscale 2016, 8, 5750–5754. [Google Scholar] [CrossRef] [PubMed]
- Yang, W.; Shen, C.; Ji, Q.; An, H.; Liu, Q.; Zhang, Z. Food storage material silver nanoparticles interfere with DNA replication fidelity and bind with DNA. Nanotechnology 2009, 20, 085102. [Google Scholar] [CrossRef] [PubMed]

| Compound | MF (M.Wt) | Color | Found (Calcd. %) | mp (°C) (Decom.) | Λm (Scm2 mol−1) | ||
|---|---|---|---|---|---|---|---|
| C | H | N | |||||
| [Ni(PVA)(P-ABA)(H2O)3]·H2O | C10H19N2NiO8 (353.89) | Light green | 34.1 33.93 | 5.74 5.41 | 8.86 7.91 | 276 | 92 |
| Assignment | PVA | P-ABA | Ni(II) Complex |
|---|---|---|---|
| O-H | 3400 | - | 3260 |
| O-Hwater | - | - | 3388 |
| N-H2 | - | 3234 | 3209 |
| C=N | - | 1640 | 1630 |
| C-OC | 1150 | - | 1176 |
| M-O | - | - | 550 |
| M-N | - | - | 440 |
| Wave Number (cm−1) | Type of Transition | Meff B.M | |
|---|---|---|---|
| Ni(II) complex | 15,740 | d-d transition | 2.59 |
| 36,630 | n→π* | ||
| 40,485 | π→π* |
| Step | Coats–Redfern | Horowitz–Metzger | ||||||
|---|---|---|---|---|---|---|---|---|
| n | r | E | Z × 102 | n | r | E | Z × 102 | |
| Second | 0.00 | 0.9918 | 20.35 | 1.39 | 0.00 | 0.9830 | 24.36 | 6.86 |
| 0.33 | 0.9972 | 32.88 | 2.26 | 0.33 | 0.9895 | 35.59 | 5.14 | |
| 0.50 | 0.9990 | 40.71 | 2.82 | 0.50 | 0.9962 | 40.41 | 1.39 | |
| 0.66 | 0.9994 | 49.71 | 3.45 | 0.66 | 0.9974 | 50.52 | 1.12 | |
| 1.00 | 0.9996 | 72.02 | 5.26 | 1.00 | 0.9976 | 70.73 | 3.07 | |
| 2.00 | 1.000 | 129.09 | 10.28 | 2.00 | 0.9996 | 120.13 | 7.68 | |
| Third | 0.00 | 0.9918 | 172.88 | 1.18 | 0.00 | 0.9830 | 171.32 | 5.53 |
| 0.33 | 0.9972 | 190.26 | 1.31 | 0.33 | 0.9895 | 192.87 | 4.47 | |
| 0.50 | 0.9990 | 211.40 | 1.46 | 0.50 | 0.9962 | 208.41 | 6.53 | |
| 0.66 | 0.9994 | 237.71 | 1.66 | 0.66 | 0.9974 | 237.70 | 7.47 | |
| 1.00 | 0.9996 | 241.94 | 1.76 | 1.00 | 0.9976 | 239.85 | 3.14 | |
| 2.00 | 1.000 | 245.39 | 1.95 | 2.00 | 0.9996 | 244.80 | 5.28 | |
| Step | ∆S* | ∆H* | ∆G* |
|---|---|---|---|
| Second | −241.98 | 21.3 | 110.42 |
| −248.54 | 32.53 | 124.07 | |
| −250.29 | 37.35 | 129.53 | |
| −250.64 | 47.46 | 139.77 | |
| −250.72 | 67.67 | 160.01 | |
| −250.95 | 117.07 | 209.49 | |
| Third | −250.80 | 21.3 | 110.42 |
| −251.13 | 32.53 | 124.07 | |
| −251.25 | 37.35 | 129.53 | |
| −251.54 | 47.46 | 139.77 | |
| −251.90 | 67.67 | 160.01 | |
| −251.09 | 117.07 | 209.49 |
| Parameters | Ni(II) Complex | Nickel Oxide (NPS) |
|---|---|---|
| Empirical formula | C10H19N2NiO8 | NiO |
| Formula weight | 353.89 | 74.68 |
| Crystal system | Cubic | Hexagonal |
| a (Å) | 7.97 | 2.95 |
| b (Å) | 7.97 | 2.95 |
| c (Å) | 7.97 | 7.24 |
| α (°) | 90 | 90 |
| β (°) | 90 | 90 |
| γ (°) | 90 | 120 |
| Volume of unit cell (Å3) | 507.35 | 54.86 |
| Particle size (nm) | - | 36 |
| Tested Organism | NiO |
|---|---|
| Staphylococcus aureus | 12 |
| Staphylococcus epidermidis | 11 |
| Enterococcus faecalis | 10 |
| Escherichia coli | 14 |
| Pseudomonas aeruginosa | 12 |
| Candida albicans | 16 |
| Aspergillus fumigatus | 15 |
| Aspergillus flavus | 12 |
Disclaimer/Publisher’s Note: The statements, opinions and data contained in all publications are solely those of the individual author(s) and contributor(s) and not of MDPI and/or the editor(s). MDPI and/or the editor(s) disclaim responsibility for any injury to people or property resulting from any ideas, methods, instructions or products referred to in the content. |
© 2025 by the authors. Licensee MDPI, Basel, Switzerland. This article is an open access article distributed under the terms and conditions of the Creative Commons Attribution (CC BY) license (https://creativecommons.org/licenses/by/4.0/).
Share and Cite
Al-Fakeh, M.S.; O. Alsaedi, R.; Aldoghaim, M.; Ibrahim, A.B.M.; Mostafa, A.M. Nickel Oxide Nanoparticles Derived from Coordination Polymer of PVA and Aminobenzoic Acid Derivative: Synthesis, Characterization and Antimicrobial Activity. Polymers 2025, 17, 301. https://doi.org/10.3390/polym17030301
Al-Fakeh MS, O. Alsaedi R, Aldoghaim M, Ibrahim ABM, Mostafa AM. Nickel Oxide Nanoparticles Derived from Coordination Polymer of PVA and Aminobenzoic Acid Derivative: Synthesis, Characterization and Antimicrobial Activity. Polymers. 2025; 17(3):301. https://doi.org/10.3390/polym17030301
Chicago/Turabian StyleAl-Fakeh, Maged S., Roaa O. Alsaedi, Maryam Aldoghaim, Ahmed B. M. Ibrahim, and Ayman M. Mostafa. 2025. "Nickel Oxide Nanoparticles Derived from Coordination Polymer of PVA and Aminobenzoic Acid Derivative: Synthesis, Characterization and Antimicrobial Activity" Polymers 17, no. 3: 301. https://doi.org/10.3390/polym17030301
APA StyleAl-Fakeh, M. S., O. Alsaedi, R., Aldoghaim, M., Ibrahim, A. B. M., & Mostafa, A. M. (2025). Nickel Oxide Nanoparticles Derived from Coordination Polymer of PVA and Aminobenzoic Acid Derivative: Synthesis, Characterization and Antimicrobial Activity. Polymers, 17(3), 301. https://doi.org/10.3390/polym17030301
